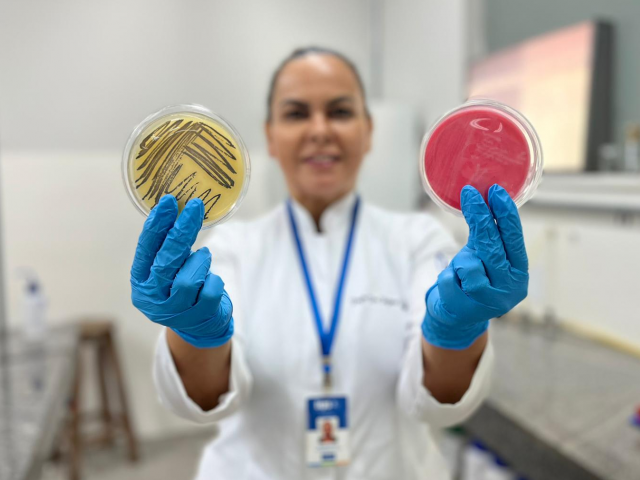

O instituto adverte que comidas típicas exigem atenção redobrada para evitar surtos de doenças alimentares
Com a chegada dos festejos juninos, a movimentação nas tradicionais barracas de comidas aumenta consideravelmente em Sergipe. Diante desse cenário, o Instituto Tecnológico e de Pesquisas do Estado de Sergipe (ITPS), órgão vinculado à Secretaria de Estado do Desenvolvimento Econômico e da Ciência e Tecnologia (Sedetec), dá orientações fundamentais para comerciantes, manipuladores de alimentos e consumidores.
De acordo com a microbiologista do ITPS e doutora em Biotecnologia, Rejane Batista, o cuidado deve começar antes mesmo do preparo. “A contaminação pode ocorrer em qualquer etapa, desde a escolha dos ingredientes até o consumo. Por isso, é fundamental que todos os envolvidos no processo estejam atentos às normas de segurança alimentar”, afirma.
Entre as orientações, Rejane destaca a importância da higiene pessoal de quem manipula os alimentos. “Lavar as mãos com frequência, usar uniformes limpos, manter as unhas curtas e evitar acessórios durante o preparo são atitudes básicas, mas que fazem toda a diferença”, explica, ao destacar que superfícies e utensílios devem ser desinfetados regularmente, os resíduos descartados corretamente, e o local de preparo precisa estar sempre limpo e organizado para evitar a proliferação de bactérias, fungos e outros micro-organismos.
As comidas típicas juninas, como pamonha, canjica, milho verde, arroz doce, paçoca e outros alimentos feitos com ingredientes como milho, leite e açúcar, exigem atenção especial. Esses alimentos, altamente nutritivos, também são mais propensos à contaminação, principalmente se não forem armazenados de forma correta. “O leite e seus derivados, bem como a carne, são meios ideais para o crescimento de micro-organismos. Por isso, devem ser refrigerados e mantidos a temperaturas abaixo de 8°C”, alerta Rejane.
A microbiologista salienta, ainda, que é comum nas festas juninas que sobrem alimentos, mas nem sempre é seguro reaproveitá-los. “Os que ficaram expostos sobre a mesa, em contato com a fala das pessoas, poeira, fumaça de fogos e outros fatores, devem ser descartados. Já os que estavam cobertos e refrigerados podem ser reaquecidos e consumidos, desde que devidamente fervidos ou refrigerados conforme o tipo de alimento”, completa.
O transporte e a comercialização também exigem cuidados. Os alimentos devem ser levados em recipientes fechados e, se necessário, refrigerados. Durante a venda, é importante manter os produtos protegidos, em temperatura adequada e evitar o manuseio direto. “Oferecer utensílios descartáveis e manter os alimentos cobertos são formas simples e eficazes de proteger o consumidor”, orienta a especialista.
Atenção aos sinais de contaminação
A gerente de atividades técnicas do ITPS, Ana Virginia Dantas, reforça a importância de denunciar suspeitas de contaminação. “Em caso de qualquer sintoma após o consumo de alimentos – como febre, diarreia, vômitos ou enxaqueca – é essencial procurar atendimento médico. O ITPS também realiza análises laboratoriais dos alimentos suspeitos. Essa colaboração é fundamental para prevenir surtos e proteger a saúde pública”, pontua.
Serviço
O ITPS realiza análises de alimentos e orientações sobre segurança alimentar. Para atendimento, o público pode procurar o Serviço de Atendimento ao Cliente (SAC) do ITPS, localizado na Rua Vila Cristina, bairro 13 de Julho, em Aracaju. Também estão disponíveis o telefone (79) 3198-8811 e o e-mail sac@itps.se.gov.br.